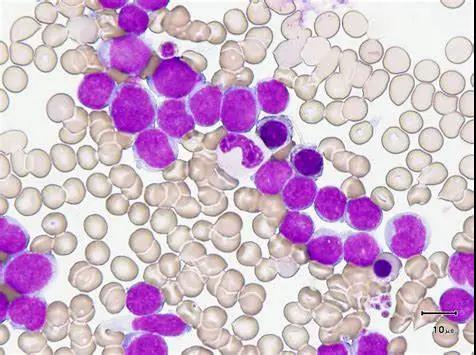
白血病融合基因檢測的意義

科普知識
-
白血病融合基因檢測的意義
發布時間:2020-08-18
白血病(Leukemia)屬于造血系統的惡性腫瘤,是一組高度異質性的惡性血液病,其特點為白血病細胞呈……
查看更多 >
-
31 2023.03血友病患者的家庭治療和護理
血友病是一組遺傳性出血性疾病,由于血漿中缺乏凝血因子Ⅷ和Ⅸ,導致凝血障礙而終生存在出血的傾向。長期反復出血不僅給患者生理和心理上帶來極大的痛苦,甚至可以造成終生殘疾或者死亡。目前,唯一有效的治療辦法就是替代治療。但是若血友……
-
28 2023.02血液病患者到底該不該接種新型冠狀病毒疫苗?
血液病患者多數存在免疫功能受損,更易感染新冠病毒,且感染后重癥率高,預后差。大規模接種新型冠狀病毒疫苗(以下簡稱"新冠疫苗"),建立群體免疫屏障是有效防控新冠疫情、降低重癥率和病死率的重要措施之一。隨著新冠病毒不斷……
-
29 2023.01“陽過”該如何消毒
最近,不少新冠病毒陽性感染者轉陰康復后,擔心家里的環境是否會藏匿病毒造成再次感染或者導致其他人感染?
-
30 2022.11人體鐵過載,什么方法可以去除?
鐵過載對人體有很多危害,如何去除人體多余的鐵,藥物有,去鐵胺,去鐵酮、地拉羅司
-
30 2022.10骨髓增生異常綜合征(MDS)鐵過載的檢查方法
骨髓增生異常綜合征(MDS)鐵過載的檢查方法有:1、血清鐵蛋白測定;2、肝活檢;3、心臟和肝臟的磁共振顯像(MRI)
-
30 2022.09骨髓增生異常綜合征(MDS)治療原則是什么?
MDS的治療原則就是解決兩大問題:1骨髓衰竭及并發癥;2、AML(急性髓系白血病的轉化)
-
30 2022.08骨髓增生異常綜合征,是一種什么病?
骨髓增生異常綜合征(MDS),是骨髓的克隆性造血干細胞、祖細胞發育異常,導致骨髓無效造血,以及惡性轉化的危險增高
-
31 2022.07多發性骨髓瘤的臨床表現
多發性骨髓瘤常見臨床表現











